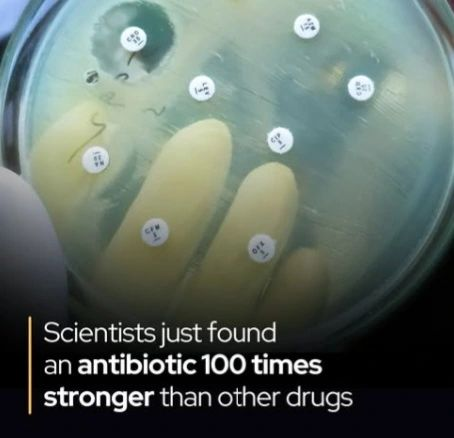
İnsanlığı Tehdit Eden Antibiyotik Direncine Karşı Yeni Gelişme!

Adını hiç duymadığınız en güçlü antibiyotik, onlarca yıldır bilim insanlarının burnunun dibinde duruyormuş!

Warwick Üniversitesi ve Monash Üniversitesi'nden bir ekip, MRSA ve VRE gibi ilaca dirençli bakterilere

Ecz Nabi DURAP
@nabi_durap
Neviyé Evdî Dûrep (Abdoyé Durap'ın torunu), Xertawî (Hartavi ailesi)
Cotkar û dermansaz (çiftçi ve eczacı)
Bavé(babası) Lûsya û Rengîné û Adar e...
ID: 1219024655144620034
19-01-2020 22:31:58
1,1K Tweet
327 Followers
1,1K Following


















An itibarıyla Suruç/ŞanlıUrfa :-) Federal Gundî


Şanlıurfa'daki EDS sistemleri aktif hale gelmeli ve üzerinde yeterince ciddi durulmalı. 70 Km hızla şehir merkezinde giden araçlara arkadan selektör yapılıyor. Sabit hız uygulaması ve ceza şart. Maalesef düzeni bazen eğitim değil ceza getiriyor. T.C. ŞANLIURFA VALİLİĞİ Şanlıurfa Emniyet Müdürlüğü